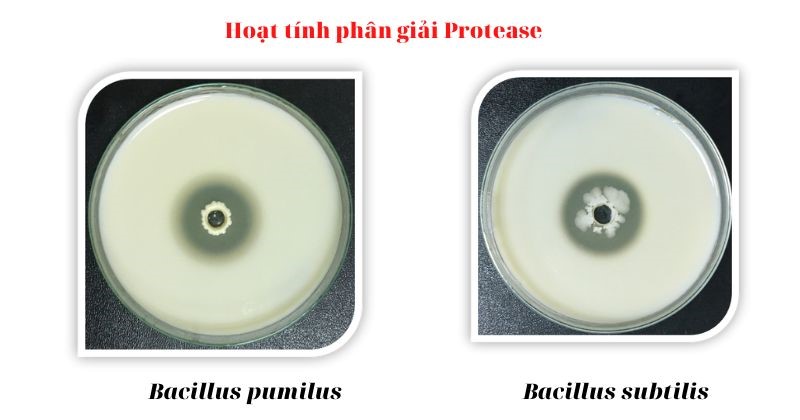
Nguyên liệu vi sinh chủng đơn của Bio-Floc
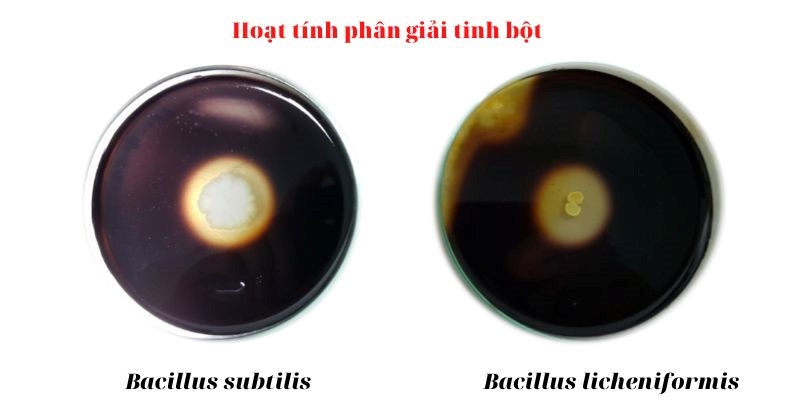

Bio-Floc là thương hiệu đã có thâm niên trong nghành sản xuất vi sinh, các chủng vi sinh được nghiên cứu bài bản trước khi cho vào sản xuất để tạo ra các sản phẩm nguyên liệu đơn chủng mật độ cao. Các nguyên liệu vi sinh chủng đơn đâm đặc này được Bio-Floc thiết kế dành riêng cho các nhà máy sản xuất thức ăn chăn nuôi, thức ăn thủy sản, nguyên liệu cho các công ty sản xuất thuốc thú y, thuốc thủy sản và chế phẩm xử lý môi trường.

Các nguyên liệu đơn chủng được sản xuất tại Bio-Flo
Contents
1. Nguyên liệu vi sinh chủng đơn đang sản xuất tại nhà máy Bio-Floc
Các nguyên liệu vi sinh chủng đơn sản xuất tại nhà máy Bio-Floc được chia thành nhiều chủng loại với nhiều công dụng khác nhau. Dưới đây là một số loại chủng vi sinh vật được dùng để sản xuất nguyên liệu:
- amyloliquefaciens KP 3: thường được dùng sản xuất men vi sinh, thức ăn vật nuôi hoặc xử lý môi trường nước… bởi khả năng xử lý chất thải với hoạt lực chủng mạnh, chịu nhiệt cao, hoạt động mạnh mẽ cả trong điều kiện oxy thấp và nhiều chất thải như ở đáy ao.
=> Mật độ: 1×109 – 1×1011cfu/g
- subtilis Ba 02: là vi khuẩn hiếu khí, tuy nhiên vẫn có thể phát triển trong môi trường thiếu khí oxy. Vi khuẩn có khả năng chịu được pH thấp, có khả năng chịu nhiệt tốt, chịu ẩm, tia tử ngoại, tia phóng xạ, áp suất, chất sát trùng,… Bacillus subtillis Ba02 được ứng dụng trong ngành công nghệ sinh học sản xuất axit amin. Chúng có khả năng ức chế sinh trưởng, tiêu diệt một số vi sinh vật gây bệnh nên được ứng dụng để tái tạo lại sự cân bằng vi khuẩn trong ruột và môi trường ao nuôi
=> Mật độ: 1×109 – 1×1011cfu/g
- licheniformis Ba 60: có khả năng chịu nhiệt cao, không tác dụng phụ, không kháng thuốc và không chứa độc tố… B. licheniformis Ba 60 giúp hỗ trợ tiêu hóa cho vật nuôi, ngăn chặn các bệnh về đường ruột để thủy sản phát triển tốt. Vi khuẩn còn giúp phân hủy chất thải, giảm các chất độc trong ao nuôi…
=> Mật độ: 1×109 – 1×1011cfu/g
- plantarum L 03: Được dùng trong các chế phẩm hỗ trợ tiêu hóa, chế phẩm xử lý ao nuôi bởi khả năng ức chế vi khuẩn gây bệnh, giúp tăng cường hệ miễn dịch, hấp thu dưỡng chất của vật nuôi. Nghiên cứu cho thấy khả năng ức chế và tiêu diệt một số vi khuẩn gây bệnh của chủng L. plantarum L 03: Kháng ecoli, kháng salmonella enterica, kháng S. aureus, kháng Vibrio sp…. là rất cao
Các chủng vi sinh vật kể trên đều được Bio-Floc giải trình tự gen 16S.

Hình ảnh phiếu phân tích kết quả giải trình tự gen
2. Hoạt tính phân giải các hợp chất hữu cơ của các chủng đơn
Tất cả các chủng vi sinh của Bio-Floc luôn được định kỳ kiểm tra khả năng sinh enzyme ngoại bào phân hủy các chất hữu cơ. Dưới đây là một số hình ảnh hoạt tính phân giải các chất hữu cơ của một số chủng đơn.
– Hoạt tính phân giải Protease: Bacillus pumilus, Bacillus subtilis…
Hoạt tính phân giải Protease
– Hoạt tính phân giải cellulose: Bacillus amyloliquefaciens, Bacillus siamensis….

Hoạt tính phân giải Cellulose
– Hoạt tính phân giải tinh bột: Bacillus subtilis, Bacillus licheniformis.
Hoạt tính phân giải tinh bột
3. Ứng dụng nguyên liệu vi sinh đơn chủng trong sản xuất các sản phẩm của các công ty thuốc thú y, thủy sản
Các nguyên liệu chủng đơn được Bio-Floc thiết kế dành riêng cho các nhà máy sản xuất thức ăn chăn nuôi, thức ăn thủy sản; nguyên liệu cho các công ty sản xuất thuốc thú y; thuốc thủy sản và chế phẩm xử lý môi trường. Các nguyên liệu đơn chủng được phối trộn với nhau theo từng công thức để tạo ra các sản phẩm với tính năng như:
3.1 Sản phẩm dùng trong nuôi trồng thủy sản
- Sản phẩm xử lý môi trường: chế phẩm xử lý nhớt bạt, chế phẩm làm sạch nước, chế phẩm xử lý đáy ao nuôi, chế phẩm xử lý khí độc, chế phẩm gây tảo, chế phẩm cắt tảo…. giúp làm sạch môi trường nước, tạo điều kiện thuận lợi để tôm, cá phát triển được tốt nhất, mang lại hiệu quả kinh tế cao.
- Sản phẩm Probiotic: chế phẩm men tiêu hóa, chế phẩm vi sinh sống… làm tăng khả năng hấp thụ chất dinh dưỡng cũng như phòng các bệnh về đường ruột, nâng cao sức đề kháng cho tôm cá. Từ đó giúp tăng năng suất tôm, cá, giảm hệ số thức ăn, giảm chi phí cho thuốc kháng sinh…

Sản phẩm Bio-Floc dùng trong nuôi trồng thủy sản
3.2 Sản phẩm dùng trong thú y
Sản phẩm khử mùi hôi chuồng trại, men tiêu hóa, men tăng trọng, sữa tắm cho thú cưng… giúp khử uế chuồng trại, ngăn mầm bệnh phát triển, tạo môi trường thuận lợi để vật nuôi sinh trưởng. Giúp vật nuôi dễ tiêu hóa thức ăn, mau ăn, chóng lớn.

Ứng dụng chế phẩm sinh học trong thú y
3.3 Sản phẩm ứng dụng trong thức ăn chăn nuôi
Nguyên liệu vi sinh đơn chủng dùng để mix cùng nguyên liệu sản xuất thức ăn chăn nuôi trước khi được ép tạo viên. Các sản phẩm được mix chế phẩm vi sinh có tác dụng giúp cho vật nuôi dễ tiêu hóa thức ăn, kích thích sinh trưởng, giảm mùi hôi chuồng trại, sinh sản và tăng cường sức đề kháng cho vật nuôi.
3.4 Sản phẩm trong môi trường
Nguyên liệu vi sinh đơn chủng được ứng dụng để sản xuất các sản phẩm phân hủy các chất thải hữu cơ, sản xuất phân vi sinh, sản phẩm xử lý rác thải… với hiệu quả vượt trội.
Trên đây là thông tin nguyên liệu vi sinh đơn chủng do Bio-Floc sản xuất, hoạt tính phân giải các hợp chất hữu cơ cũng như tính ứng dụng nguyên liệu vi sinh đơn chủng trong sản xuất. Bio-Floc là đơn vị uy tín, chuyên cung cấp các nguyên liệu đơn chủng cho các đối tác lớn. Hãy liên hệ ngay Bio-Floc chúng tôi để có giải pháp tốt nhất cho các sản phẩm, chế phẩm vi sinh của quý vị.
Thông tin liên hệ:
𝐂𝐨̂𝐧𝐠 𝐭𝐲 𝐓𝐍𝐇𝐇 𝐁𝐢𝐨-𝐅𝐥𝐨𝐜
- Địa chỉ: Cụm CN Liên Hiệp – Phúc Thọ – Hà Nội
- Web: http://biofloc.vn/
- Hotline: 𝟎𝟖𝟐𝟖. 𝟗𝟗. 𝟖𝟔𝟖𝟔
- Email: biofloccompany@gmail.com

